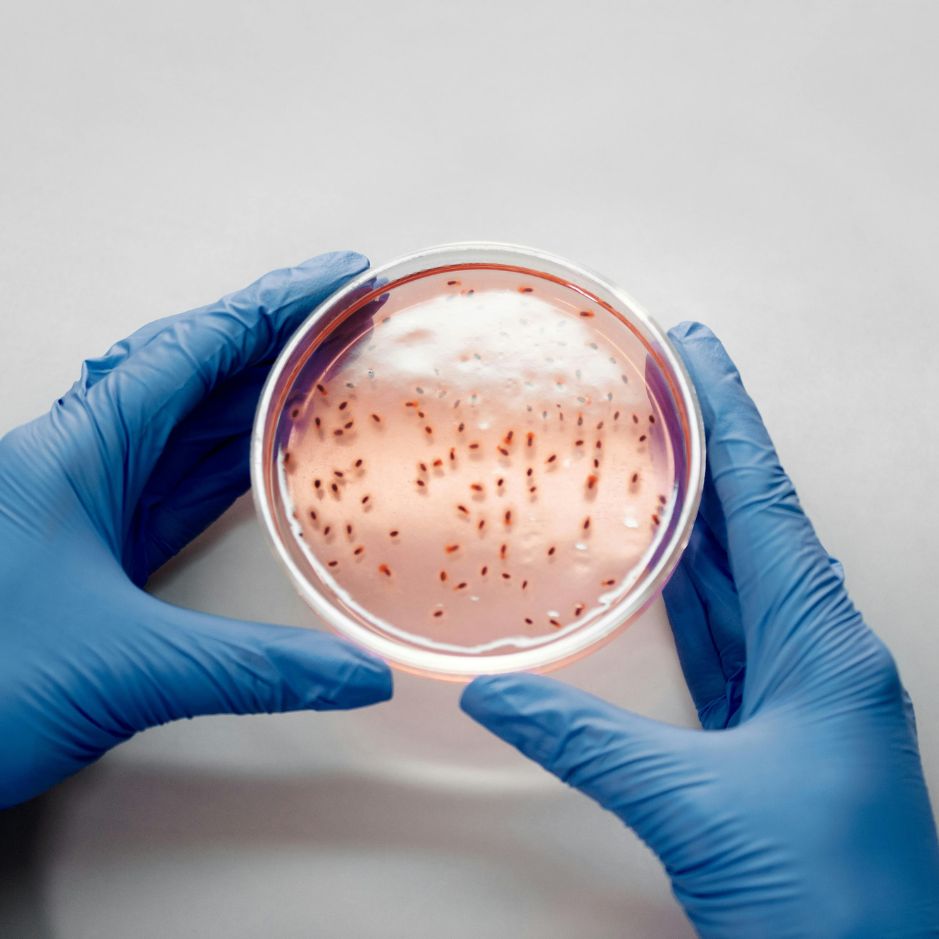

GENETIC INSIGHTS FOR HORMONAL HEALTH
Clarity on Genetic Hormone Pathways: See what influences key steroid hormone processes for reproductive, metabolic & immune function.
Insights Into Hormone-Related Concerns: Understand genetic factors linked to low testosterone, PCOS, or other hormonal imbalances.
Guidance for Personalised Health Choices: Use genetic insights for proactive nutrition & lifestyle strategies that support hormonal balance.

Perspective from Dr Enayat
“Steroid hormones play vital roles in energy, reproduction, metabolism and immune function. By understanding the genetic variations that influence these pathways, individuals gain meaningful insight into how their bodies regulate hormones. This enables more personalised and proactive approach.”

WHY GENETIC INSIGHTS FOR HORMONE HEALTH?